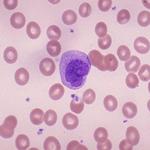

Другие названия и синонимы
Monocytopenia.
Описание
Моноцитопения. Это лабораторный синдром, при котором наблюдается снижение уровня моноцитов ниже 500 в 1 л крови. Изолированная моноцитопения встречается крайне редко. Чаще всего это связано с уменьшением количества нейтрофилов (нейтропения) или снижением содержания всех клеток крови (панцитопения). Причиной моноцитопении могут быть тяжелые бактериальные инфекции, злокачественные миелопролиферативные заболевания, угнетение кроветворения и Уровень моноцитов изучается при подсчете лейкоцитарной формулы в клиническом анализе крови. Коррекция этого состояния проводится при лечении основного заболевания.
|
|
Причины
Уменьшение количества моноцитов в периферической крови не всегда свидетельствует о наличии заболевания или патологического состояния. В некоторых случаях у женщин в раннем послеродовом периоде может наблюдаться моноцитопения, не требующая лечения. Уровень моноцитов нормализуется самостоятельно уже через 2-3 дня после родов.
Бактериальные инфекции - наиболее частая причина моноцитопении. Некоторые бактерии, например пиогенные (стафилококки, стрептококки), способны выделять токсины, подавляющие процесс кроветворения в кроветворных клетках костного мозга. Сначала, как правило, происходит снижение уровня нейтрофилов (нейтропения), затем, по мере прогрессирования инфекции и ее генерализации, количество моноцитов уменьшается.
Развитие моноцитопении свидетельствует о тяжелом течении болезни и является маркером неблагоприятного прогноза. После антибактериальной терапии и устранения инфекционного очага уровень моноцитов постепенно приходит в норму в течение нескольких дней. Инфекции, сопровождающиеся моноцитопенией:
• Гнойно-септические процессы. Абсцесс, флегмона, сибирская язва.
• Специфические инфекции. Брюшной тиф (гипертоксическая форма), риккетсиозы (сыпной тиф).
Иногда моноцитопения может возникнуть в результате медицинского вмешательства. Например, у некоторых пациентов снижение уровня моноцитов наблюдается в первые сутки после операции, их количество возвращается к нормальным значениям через 4-5 дней. Кроме того, после химиотерапии часто возникает моноцитопения, связанная со снижением содержания других лейкоцитов.
Чаще всего моноцитопения развивается на фоне длительного приема глюкокортикоидов. Эти гормональные препараты широко используются, их назначают для лечения большого количества заболеваний, в основном аутоиммунных (болезнь Крона, системная красная волчанка, анкилозирующий спондилит), дерматологических (экзема, псориаз), аллергических (бронхиальная астма) и.
Несмотря на то, что многие миело- и лимфопролиферативные заболевания сопровождаются моноцитозом (увеличением количества моноцитов), моноцитопения является очень характерным признаком волосатоклеточного лейкоза. Это наблюдается почти у 90% пациентов. Волосатоклеточный лейкоз - это хроническое В-клеточное лимфопролиферативное заболевание неизвестной этиологии, поражающее костный мозг и селезенку.
Основные клинические симптомы данной патологии - увеличение селезенки и периферических лимфатических узлов. В крови наблюдаются тромбоцитопения, анемия, лейкопения за счет моноцитов и нейтрофилов. Моноцитопения начинает развиваться постепенно и будет сохраняться до тех пор, пока не будет назначено специальное лечение. Нормализация количества моноцитов - один из критериев успешной химиотерапии.
Это заболевание может носить как наследственный, так и приобретенный характер, и характеризуется замещением костного мозга жировой тканью. В результате подавляется образование всех клеток крови (панцитопения). Кроме того, в клиническую картину входят гепатоспленомегалия, лимфаденопатия. На ранних стадиях апластической анемии может возникнуть моноцитопения, что часто требует дифференциальной диагностики с волосатоклеточным лейкозом (HCL).
В редких случаях моноцитопения может быть вызвана генетической мутацией. GATA 2 представляет собой ген гемопоэтического фактора транскрипции, который экспрессируется в стволовых клетках костного мозга. Дефицит GATA 2 - это группа различных заболеваний с высокой смертностью, вызванная общим генетическим дефектом. В результате мутации в организме человека резко уменьшается количество дендритных клеток, лимфоцитов и моноцитов.
Эти пациенты очень восприимчивы к вирусным и бактериальным инфекциям. У них повышенный риск развития злокачественных новообразований, миелодиспластического синдрома, лейкемии и лимфом. Моноцитопения сохраняется до тех пор, пока пациенту не сделают трансплантацию костного мозга.
Бактериальные инфекции - наиболее частая причина моноцитопении. Некоторые бактерии, например пиогенные (стафилококки, стрептококки), способны выделять токсины, подавляющие процесс кроветворения в кроветворных клетках костного мозга. Сначала, как правило, происходит снижение уровня нейтрофилов (нейтропения), затем, по мере прогрессирования инфекции и ее генерализации, количество моноцитов уменьшается.
Развитие моноцитопении свидетельствует о тяжелом течении болезни и является маркером неблагоприятного прогноза. После антибактериальной терапии и устранения инфекционного очага уровень моноцитов постепенно приходит в норму в течение нескольких дней. Инфекции, сопровождающиеся моноцитопенией:
• Гнойно-септические процессы. Абсцесс, флегмона, сибирская язва.
• Специфические инфекции. Брюшной тиф (гипертоксическая форма), риккетсиозы (сыпной тиф).
Иногда моноцитопения может возникнуть в результате медицинского вмешательства. Например, у некоторых пациентов снижение уровня моноцитов наблюдается в первые сутки после операции, их количество возвращается к нормальным значениям через 4-5 дней. Кроме того, после химиотерапии часто возникает моноцитопения, связанная со снижением содержания других лейкоцитов.
Чаще всего моноцитопения развивается на фоне длительного приема глюкокортикоидов. Эти гормональные препараты широко используются, их назначают для лечения большого количества заболеваний, в основном аутоиммунных (болезнь Крона, системная красная волчанка, анкилозирующий спондилит), дерматологических (экзема, псориаз), аллергических (бронхиальная астма) и.
Несмотря на то, что многие миело- и лимфопролиферативные заболевания сопровождаются моноцитозом (увеличением количества моноцитов), моноцитопения является очень характерным признаком волосатоклеточного лейкоза. Это наблюдается почти у 90% пациентов. Волосатоклеточный лейкоз - это хроническое В-клеточное лимфопролиферативное заболевание неизвестной этиологии, поражающее костный мозг и селезенку.
Основные клинические симптомы данной патологии - увеличение селезенки и периферических лимфатических узлов. В крови наблюдаются тромбоцитопения, анемия, лейкопения за счет моноцитов и нейтрофилов. Моноцитопения начинает развиваться постепенно и будет сохраняться до тех пор, пока не будет назначено специальное лечение. Нормализация количества моноцитов - один из критериев успешной химиотерапии.
Это заболевание может носить как наследственный, так и приобретенный характер, и характеризуется замещением костного мозга жировой тканью. В результате подавляется образование всех клеток крови (панцитопения). Кроме того, в клиническую картину входят гепатоспленомегалия, лимфаденопатия. На ранних стадиях апластической анемии может возникнуть моноцитопения, что часто требует дифференциальной диагностики с волосатоклеточным лейкозом (HCL).
В редких случаях моноцитопения может быть вызвана генетической мутацией. GATA 2 представляет собой ген гемопоэтического фактора транскрипции, который экспрессируется в стволовых клетках костного мозга. Дефицит GATA 2 - это группа различных заболеваний с высокой смертностью, вызванная общим генетическим дефектом. В результате мутации в организме человека резко уменьшается количество дендритных клеток, лимфоцитов и моноцитов.
Эти пациенты очень восприимчивы к вирусным и бактериальным инфекциям. У них повышенный риск развития злокачественных новообразований, миелодиспластического синдрома, лейкемии и лимфом. Моноцитопения сохраняется до тех пор, пока пациенту не сделают трансплантацию костного мозга.

Диагностика
В связи с широким спектром этиологических факторов моноцитопении для ее выявления в анализе крови требуется посещение терапевта. На приемной проводится опрос пациента и сбор анамнестических данных. Определяется, стоит ли пациент на учете в поликлинике и принимает ли он гормональные препараты. Для выявления симптомов, которые могут помочь сузить дифференциальный диагноз причин моноцитопении, проводится тщательное физикальное обследование.
Измеряется температура тела, артериальное давление, пульс. Кожу и слизистые оболочки исследуют на предмет бледности, наличия кровоизлияний (экхимозов, экхимозов). Производится пальпация периферических лимфатических узлов, печени и селезенки. Также назначаются дополнительные методы исследования:
• Общий анализ крови. В анализе крови может быть повышенная СОЭ, лейкоцитоз (при инфекциях) или, наоборот, анемия, тромбоцитопения, лейкопения. При микроскопии мазка крови у больных с септическими процессами выявляются морфологические изменения лейкоцитов - токсигенная зернистость нейтрофилов, вакуолизация цитоплазмы. Характерным признаком GDL считаются «волосатые лимфоциты» с ворсинчатыми отростками.
• Химия крови. При проведении биохимических тестов выявляется повышение содержания С-реактивного белка, лактатдегидрогеназы.
• Микробиологические исследования. Для выявления инфекционного возбудителя и назначения таргетной антибактериальной терапии проводится бактериальный посев для определения чувствительности к антибиотикам.
• Иммунологические исследования. Пациенты с подозрением на генерализацию гнойных инфекций и При развитии сепсиса необходим анализ на прокальцитонин и пресепсин.
• Проточной цитометрии. Этот метод диагностики позволяет установить иммунофенотип опухолевых лимфоцитов у пациентов с HCL путем выявления экспрессии различных маркеров (CD19, сD20, сD22). Кроме того, с помощью проточной цитометрии у пациентов с апластической анемией (АК) можно выявить иммунофенотипические признаки дисмиелоза и определить наличие клона ПНГ.
• Гистологические исследования. Трепанобиопсия необходима для подтверждения ПО и АА. При ON аспират костного мозга показывает диффузную инфильтрацию лимфоидными клетками с ядром неправильной формы и большой цитоплазмой. Для АА характерна следующая картина - небольшое количество кроветворных клеток, межтрабекулярные промежутки заполнены жиром.
• Генетические исследования. Мутация гена GATA 2 установлена с помощью ПЦР-анализа, секвенирования и кариотипирования.
• УЗИ. УЗИ органов брюшной полости у пациентов с гематологическими заболеваниями выявляет увеличение размеров печени и селезенки.
Сбор крови для лабораторных исследований.
Измеряется температура тела, артериальное давление, пульс. Кожу и слизистые оболочки исследуют на предмет бледности, наличия кровоизлияний (экхимозов, экхимозов). Производится пальпация периферических лимфатических узлов, печени и селезенки. Также назначаются дополнительные методы исследования:
• Общий анализ крови. В анализе крови может быть повышенная СОЭ, лейкоцитоз (при инфекциях) или, наоборот, анемия, тромбоцитопения, лейкопения. При микроскопии мазка крови у больных с септическими процессами выявляются морфологические изменения лейкоцитов - токсигенная зернистость нейтрофилов, вакуолизация цитоплазмы. Характерным признаком GDL считаются «волосатые лимфоциты» с ворсинчатыми отростками.
• Химия крови. При проведении биохимических тестов выявляется повышение содержания С-реактивного белка, лактатдегидрогеназы.
• Микробиологические исследования. Для выявления инфекционного возбудителя и назначения таргетной антибактериальной терапии проводится бактериальный посев для определения чувствительности к антибиотикам.
• Иммунологические исследования. Пациенты с подозрением на генерализацию гнойных инфекций и При развитии сепсиса необходим анализ на прокальцитонин и пресепсин.
• Проточной цитометрии. Этот метод диагностики позволяет установить иммунофенотип опухолевых лимфоцитов у пациентов с HCL путем выявления экспрессии различных маркеров (CD19, сD20, сD22). Кроме того, с помощью проточной цитометрии у пациентов с апластической анемией (АК) можно выявить иммунофенотипические признаки дисмиелоза и определить наличие клона ПНГ.
• Гистологические исследования. Трепанобиопсия необходима для подтверждения ПО и АА. При ON аспират костного мозга показывает диффузную инфильтрацию лимфоидными клетками с ядром неправильной формы и большой цитоплазмой. Для АА характерна следующая картина - небольшое количество кроветворных клеток, межтрабекулярные промежутки заполнены жиром.
• Генетические исследования. Мутация гена GATA 2 установлена с помощью ПЦР-анализа, секвенирования и кариотипирования.
• УЗИ. УЗИ органов брюшной полости у пациентов с гематологическими заболеваниями выявляет увеличение размеров печени и селезенки.
Сбор крови для лабораторных исследований.
|
|
Лечение
Сама по себе моноцитопения может не нуждаться в лечении, как в случае хронического приема глюкокортикоидов. Необходимо проводить терапию основной патологии, на фоне которой возникла моноцитопения. Поскольку этиология уменьшения количества моноцитов - довольно серьезное заболевание, во время лечения пациента следует госпитализировать под наблюдением врача. Используются следующие методы консервативной терапии:
• Антибактериальная терапия. При гнойно-септических процессах назначают антибиотики из группы пенициллинов, цефалоспоринов или аминогликозидов. При риккетсиозе и брюшном тифе предпочтение отдается фторхинолонам, тетрациклинам или макролидам.
• Химиотерапия. Для устранения клона опухоли и достижения ремиссии в HCL используются аналоги нуклеозидов. Цитостатические препараты применяют у пациентов с апластической анемией.
• Стимуляторы кроветворения. Для активации процессов кроветворения пациентам с АК назначают колониестимулирующие факторы, стимуляторы образования тромбоцитов, эритроцитов.
• Биологические препараты генной инженерии. Моноклональные антитела против лимфоцитарного антигена сD 52 и антитимоцитарного глобулина, полученные путем иммунизации животных лимфоцитами человека, также очень эффективны для лечения АК.
• Переливание крови. Больным с гематологическими заболеваниями часто показаны переливания цельной крови или ее компонентов: эритроцитарной массы, концентрата тромбоцитов.
Больным с абсцессами, флегмонами вскрывают и дренируют гнойный очаг. При сильной спленомегалии удаляют селезенку. Поскольку после спленэктомии увеличивается риск заражения некоторыми бактериальными инфекциями, перенесшие эту операцию люди должны быть вакцинированы против пневмококка, менингококка, Haemophilus influenzae.
Трансплантация гемопоэтических стволовых клеток позволяет полностью излечить АА и НА. Однако, учитывая риск развития опасной для жизни реакции трансплантат против хозяина, эта операция назначается не всем пациентам, а только по четким показаниям. Трансплантация костного мозга также выполняется пациентам с дефицитом GATA 2.
• Антибактериальная терапия. При гнойно-септических процессах назначают антибиотики из группы пенициллинов, цефалоспоринов или аминогликозидов. При риккетсиозе и брюшном тифе предпочтение отдается фторхинолонам, тетрациклинам или макролидам.
• Химиотерапия. Для устранения клона опухоли и достижения ремиссии в HCL используются аналоги нуклеозидов. Цитостатические препараты применяют у пациентов с апластической анемией.
• Стимуляторы кроветворения. Для активации процессов кроветворения пациентам с АК назначают колониестимулирующие факторы, стимуляторы образования тромбоцитов, эритроцитов.
• Биологические препараты генной инженерии. Моноклональные антитела против лимфоцитарного антигена сD 52 и антитимоцитарного глобулина, полученные путем иммунизации животных лимфоцитами человека, также очень эффективны для лечения АК.
• Переливание крови. Больным с гематологическими заболеваниями часто показаны переливания цельной крови или ее компонентов: эритроцитарной массы, концентрата тромбоцитов.
Больным с абсцессами, флегмонами вскрывают и дренируют гнойный очаг. При сильной спленомегалии удаляют селезенку. Поскольку после спленэктомии увеличивается риск заражения некоторыми бактериальными инфекциями, перенесшие эту операцию люди должны быть вакцинированы против пневмококка, менингококка, Haemophilus influenzae.
Трансплантация гемопоэтических стволовых клеток позволяет полностью излечить АА и НА. Однако, учитывая риск развития опасной для жизни реакции трансплантат против хозяина, эта операция назначается не всем пациентам, а только по четким показаниям. Трансплантация костного мозга также выполняется пациентам с дефицитом GATA 2.

Прогноз
Моноцитопения считается показателем глубокого угнетения лейкопоэза и нарушения функционирования ретикулоэндотелиальной системы. Следовательно, он часто является маркером тяжелого течения болезни и предиктором неблагоприятного прогноза. Эти факторы определяют чрезвычайную важность своевременного выявления этиологии его возникновения, диагностики и лечения.